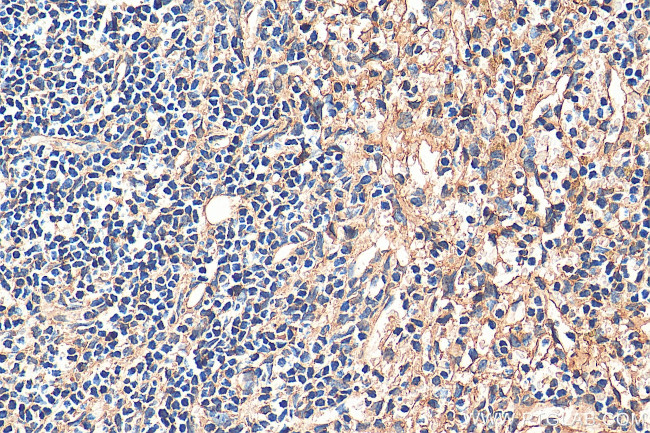
STIM2 Antibody in Immunohistochemistry (Paraffin) (IHC (P))
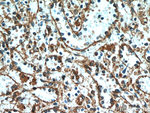
STIM2 Antibody in Immunohistochemistry (Paraffin) (IHC (P))

Search
Proteintech
STIM2 Polyclonal Antibody
{{$productOrderCtrl.translations['antibody.pdp.commerceCard.promotion.promotions']}}
{{$productOrderCtrl.translations['antibody.pdp.commerceCard.promotion.viewpromo']}}
{{$productOrderCtrl.translations['antibody.pdp.commerceCard.promotion.promocode']}}: {{promo.promoCode}} {{promo.promoTitle}} {{promo.promoDescription}}. {{$productOrderCtrl.translations['antibody.pdp.commerceCard.promotion.learnmore']}}
产品信息
21192-1-AP
种属反应
已发表种属
宿主/亚型
分类
类型
抗原
偶联物
形式
浓度
规格
纯化类型
保存液
内含物
保存条件
运输条件
产品详细信息
Immunogen sequence: EKICGFQIA HNSGLPSLTS SLYSDHSWVV MPRVSIPPYP IAGGVDDLDE DTPPIVSQFP GTMAKPPGSL ARSSSLCRSR RSIVPSSPQP QRAQLAPHAP HPSHPRHPHH PQHTPHSLPS PDPDILSVSS CPALYRNEEE EEAIYFSAEK Q (525-674 aa encoded by BC146661)
靶标信息
In T lymphocytes, the sole pathway for Ca++ entry following antigen-receptor binding is through store-operated Ca++-release-activated Ca++ (CRAC) channels. These channels are made up of the pore-forming subunit ORAI1 and the stromal interaction molecule 1 (STIM1), a protein that functions as a Ca++ sensor and activates the CRAC channels, migrating to the plasma membrane from endoplasmic reticulum (ER)-like sites which act as the Ca++ store. A related molecule, STIM2, acts to inhibit the STIM1-mediated store-operated Ca++ entry, and can form complexes with STIM1, suggesting they may play a coordinated role in controlling Ca++ entry. At least three isoforms of STIM2 are known to exist.
仅用于科研。不用于诊断过程。未经明确授权不得转售。
生物信息学
蛋白别名: OTTHUMP00000123457; OTTHUMP00000123458; OTTHUMP00000216198; Stromal interaction molecule 2; transmembrane protein; unnamed protein product
基因别名: KIAA1482; STIM2
UniProt ID: (Human) Q9P246, (Mouse) P83093
Entrez Gene ID: (Human) 57620, (Mouse) 116873, (Rat) 117087